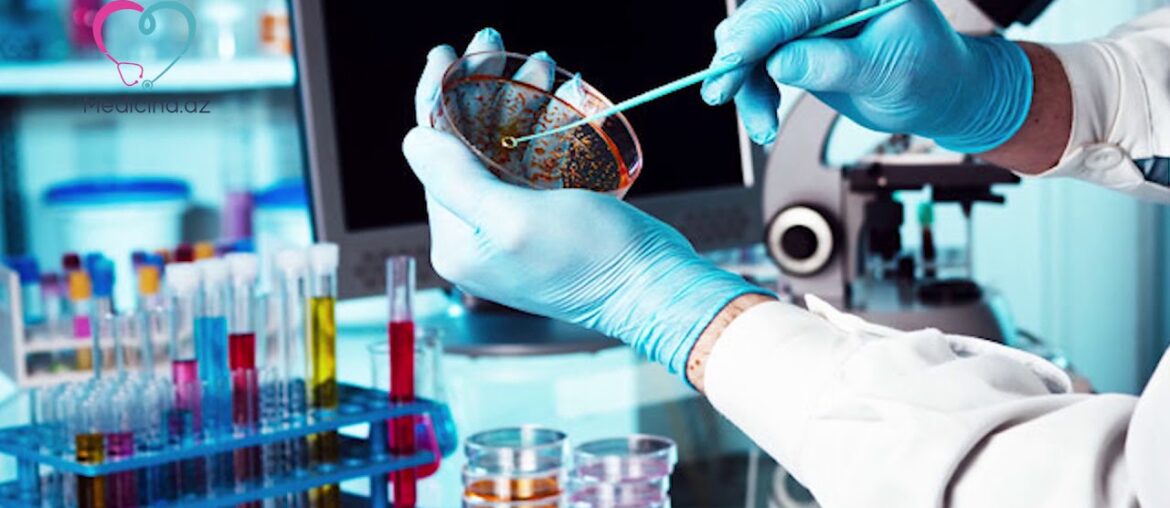
Alimlər bu vitaminin COVID-19-un gedişatını yüngülləşdirdiyini bildirir

Buraya ➡ tıklayarak uzaktan eğitim başvuru formunu doldurabilirsiniz. Buraya ➡ tıklayarak abone olup zile tıklayıp tüm bildirimleri açabilirsiniz. En güncel fitness soru cevap ve fitness bilgi videolarım 👇 🔥İhtiyaç Sahiplerine Yaptığımız Yardımlar ➡ 🔥Boy Uzatma Egzersizleri ➡ 🔥Bir Kas Gurubu…